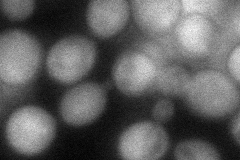
YDR272W
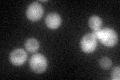
YDR272W

View description
Cytoplasmic glyoxalase II, catalyzes the hydrolysis of S-D-lactoylglutathione into glutathione and D-lactate
Localization:
Intensity:
Fold change:
Significance:
-
C’ GFP library in SD

cytosol51.21 -
N' NOP1pr-GFP in SD

cytosol150.844 -
N' TEF2pr-mCherry in SD

cytosol195.575 -
N' NATIVEpr-GFP in SD

cytosol63.7395 -
N' TEF2pr-VC and Cyto-VN in SD
cytosol54.4888 -
C’ GFP library in SD+DTT

cytosol69.331.35Yes -
C’ GFP library in SD+H2O2
cytosol60.791.18No -
C’ GFP library in Starvation Media

cytosol68.961.34Yes -
C’ GFP library on the background of Pup2-DaMP

cytosol -
C’ GFP library on the background of CCT mutant

cytosol52.02261.01577No
